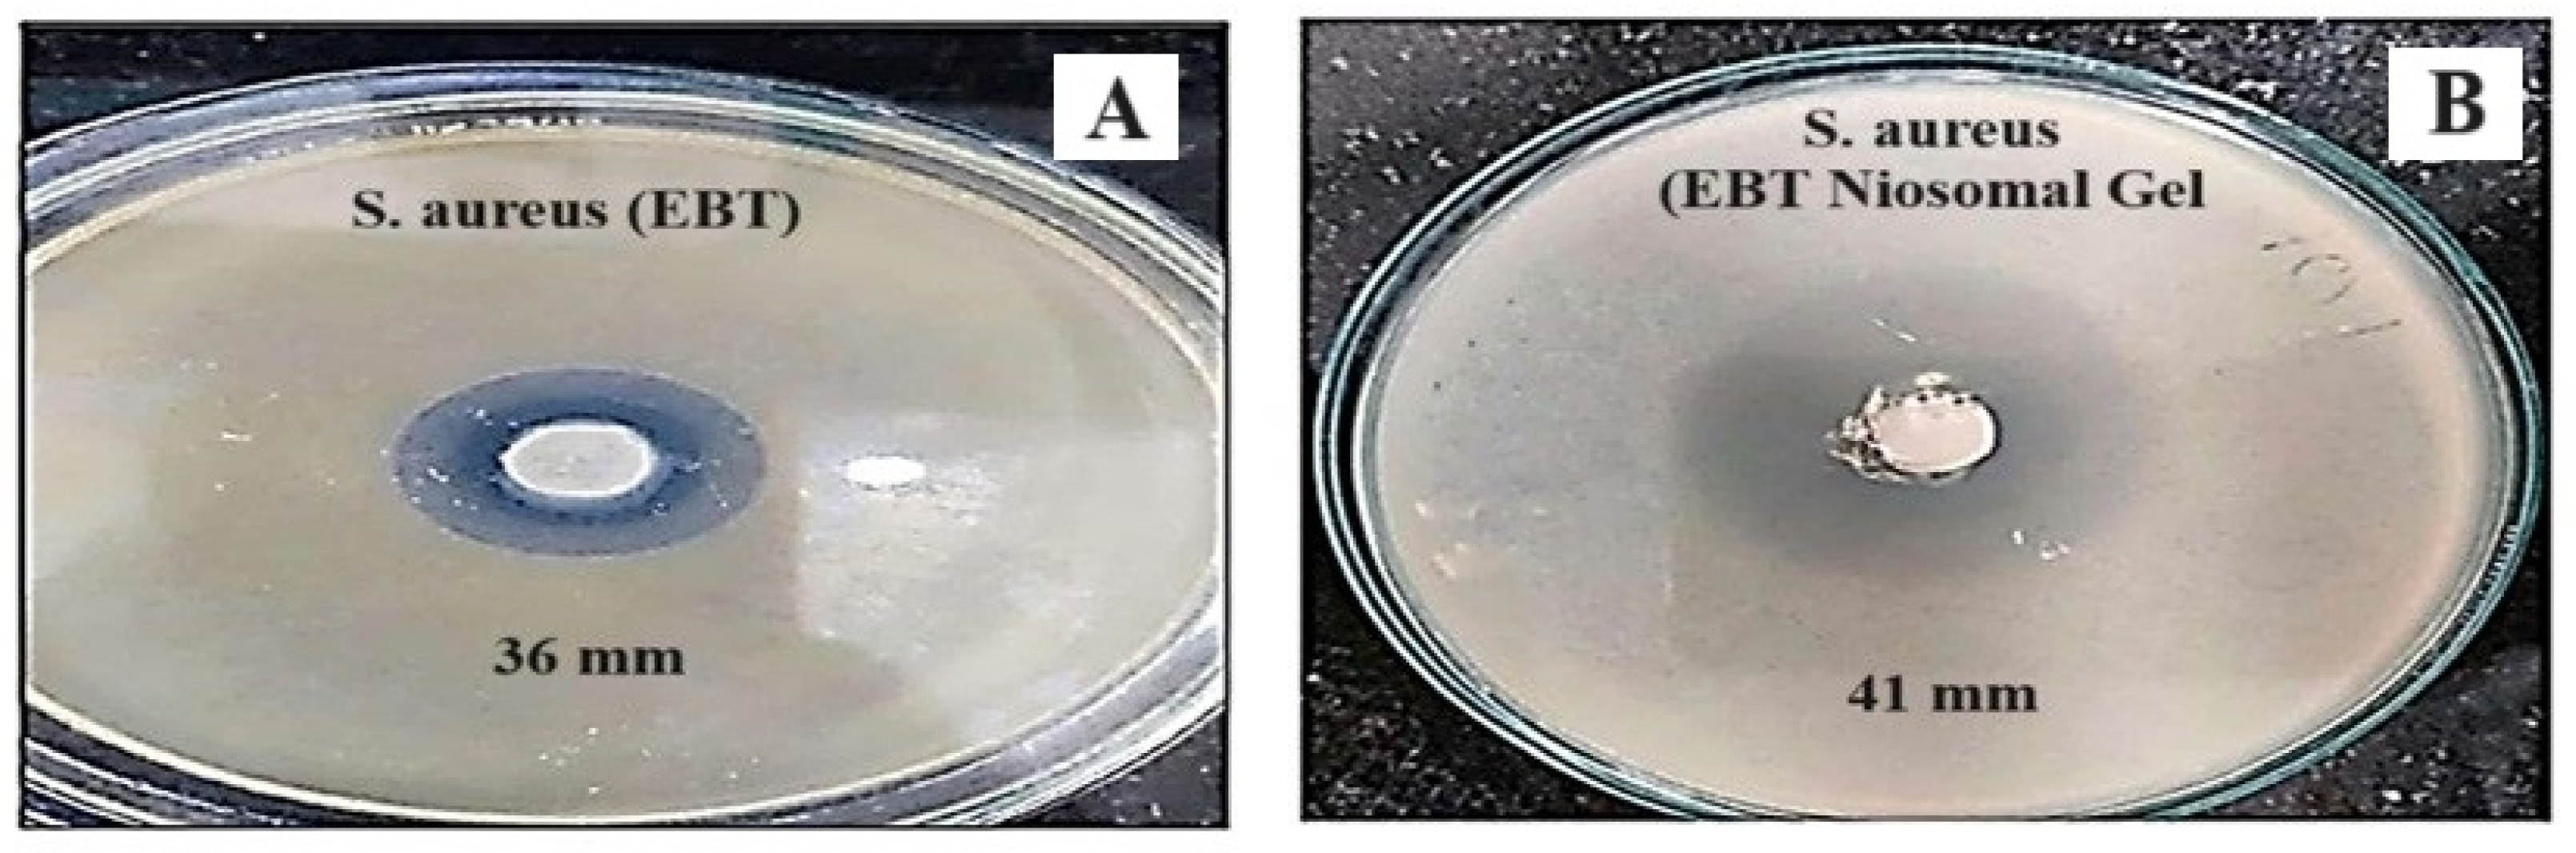
Blsf 38 00009 g008

1. Introduction
Recent research has focused on enhancing patient compliance and therapeutic efficacy through the development of innovative drug delivery methods. Despite the development of numerous methods with improved therapeutic effects, challenges remain [
1]. The gastrointestinal (GI) tract presents an unfavorable environment for oral medications due to variations in pH, solubility issues, and first-pass metabolism, where many drugs metabolize under acidic or alkaline conditions. Parenteral preparations have drawbacks such as hypersensitivity, infection risks, lack of reversibility, and high costs. In contrast, transdermal drug delivery systems offer significant advantages by bypassing the GI tract, thereby avoiding pH variability and first-pass metabolism issues. They provide controlled release through the skin, enhancing bioavailability, reducing side effects, and improving patient compliance by eliminating the need for frequent dosing [
2,
3].
Niosomes, which utilize cholesterol and non-ionic surfactants, offer a safe and effective drug delivery system. They self-assemble into vesicles capable of encapsulating both hydrophilic and hydrophobic drugs, thereby enhancing bioavailability, especially for poorly soluble medications [
4,
5,
6]. Niosomal gel, which provides a controlled release and improves patient compliance, helps mitigate issues related to gastrointestinal absorption and enzymatic interactions. Ebastine, a long-acting histamine H1 receptor antagonist effective against conditions like atopic dermatitis and allergic rhinitis, benefits from this delivery method despite its classification as a BCS class II drug with low oral bioavailability [
7,
8,
9].
Ebastine, a non-sedating, long-acting histamine H1 receptor antagonist, is used to treat conditions such as atopic dermatitis, chronic idiopathic urticaria, and allergic rhinitis. It belongs to BCS class II with poor oral bioavailability. Allergic processes occur when the immune system mistakenly identifies harmless substances (allergens) as threats. The process unfolds in two main phases: Sensitization: the first time the body encounters an allergen, the immune system produces IgE antibodies, which bind to mast cells and basophils (immune cells). Subsequent exposure: when the body encounters the same allergen again, the allergen binds to the IgE on mast cells, triggering the release of histamine and other chemicals. These substances cause typical allergy symptoms like itching, swelling, hives, and inflammation. Chronic exposure can lead to long-term inflammation and conditions like asthma or allergic rhinitis [
10]. Urticaria affects 12–22% of the population worldwide, more commonly in women than men, and can occur at any age, characterized by wheals and flares that can last from hours to months depending on allergens. This study aimed to formulate, optimize, characterize, and assess the in vitro performance of an ebastine-loaded niosomal nanogel to enhance its bioavailability [
10,
11].
2. Material and Methods
Ebastine was received as a gift sample from Micro Labs Pvt. Ltd., Mumbai, Maharashtra, India. Cholesterol, Tween 80, Span 60, Carbopol 934, methanol, and propylene glycol were purchased from Research-Lab Fine Chem Industries, Mumbai, Maharashtra, India. Phosphate Buffer saline (PBS) pH 7.4 was prepared as described in the I.P. 1996.
2.1. Preparation and Statistical Optimization of Ebastine-Loaded Niosomes
2.1.1. Preparation of Ebastine-Loaded Niosomes
A thin film is formed by dissolving a mixture of the drug, non-ionic surfactant, cholesterol, and organic solvent (methanol) as detailed in (
Table 1). The organic solvent is then evaporated using a rotary evaporator (SuperfitRotavap—PBU 6D) at 60 °C, rotating at 60 rpm for 1 h. The resulting thin film is hydrated with phosphate buffer (pH 7.4) and left overnight to allow for the vesicles to swell. The swollen vesicles are subsequently sonicated at room temperature for 5–10 min to form small unilamellar vesicles (
Figure 1) [
9,
12,
13].
The prepared niosomes were optimized using parameters such as TEM analysis, entrapment efficiency, polydispersity index, and zeta potential. The optimized niosomes were then used for further characterization [
14,
15].
2.1.2. Box–Behnken Design (BBD) Experiment
In this study, the formulation variables for Ebastine-loaded niosomes were optimized using a Box–Behnken design with three factors assessed at two levels each. Cholesterol, a non-ionic surfactant (Span 60), and the volume of the hydration medium were chosen as independent variables, while entrapment efficiency (Y1), zeta potential (Y2), and vesicle size (Y3) were the dependent responses.
Table 2 lists the independent factors and their ranges used in the investigation. The experiments were designed using DOE software (Version 13.0.5.0), with the design arrangement shown in (
Table 3), creating a total of 13 formulations [
16].
2.2. Preparation of Nanogel Loaded with Ebastine Niosomes
The gel was prepared using the dispersion method: Carbopol 934 was gradually introduced into distilled water and allowed to hydrate for 24 h. For the niosomal gel, optimized niosomes were added to hydrated Carbopol 934 on a magnetic stirrer (REMI1MLH) with propylene glycol, resulting in 1.2% (
w/
w) Ebastine niosomal gel. The gel’s pH was adjusted to 6–7 using triethanolamine, and distilled water was added for final adjustment. Various gel batches (
Table 4) were prepared by varying Carbopol concentrations from 0.5% to 2.0% [
16].
2.3. Characterization of Formulation Batches [16,17]
2.3.1. Drug–Excipient Compatibility Study by Fourier Transform Infra-Red (FTIR) Spectroscopy
The IR spectra of the pure drug and excipients along with the mixture of the drug and excipients were recorded by FTIR and the compatibility of the drug and excipients was checked by comparing the spectra.
2.3.2. Particle Size Distribution and Polydispersity Index (PDI) Determined by Using Zeta-Sizer
The particle size and PDI were determined by using a zeta sizer for uniformity of size.
2.3.3. Zeta Potential and Surface Charge
Zeta potential was determined using a Zeta-sizer. The measurement of the electrophoretic mobility of particles in dispersion under an applied electric field was performed using the technique known as Electrophoretic Light Scattering (ELS).
2.3.4. Gel Properties
Homogeneity
Niosomal gels placed in a transparent, clear beaker were tested for homogeneity by visual examination.
It was also tested for its physical appearance and the presence of any aggregates.
Grittiness
Gels were checked microscopically for the presence of any visible particulate matter.
Measurement of pH
A digital pH meter was used to determine the pH value. An amount of 2.5 g of gel was dispersed in 25 mL of distilled water, and the measurement was performed.
Viscosity Measurement
The viscosity of the gels was measured with a Brookfield viscometer DV2T model using a Helipath T spindle-D 95. An amount of 100 gm of gel was taken in a clear beaker for the measurement of viscosity.
Spreadability
The “maximum slip and minimum drag” principle was used to determine the spreadability of niosomal gels. A surplus of gel formulation was sandwiched within two glass slides. Weight can be put on the top slide to ensure homogeneous gel dispersion. The weight was removed, and the extra gel sticking to the slides’ borders was scraped away. The wooden board was used to secure the lower slide. The top of the slide was held in place by a rope connected with a pan. The line was passed through a mechanism called a pulley, and the pan was suspended from it. Following that, a weight was placed on the pan and the top slide was pulled with the aid of a thread. The time it takes for the top slide to slip over the lower slide is recorded and used as an estimate of spreadability.
Extrudability
The extrudability of the gel was determined using a closed collapsible tube in which the formulation was filled and pressed firmly at the crimped end. The weight of the tube was recorded. The tube was placed in two glass slides and some weight was placed on the slides, and then the cap was removed. The amount of extruded gel was recorded.
Percent Drug Content
An amount of 1 gm of each gel preparation was dissolved in methanol (10 mL). The process of serial dilutions was used to create appropriate aliquots of different concentrations. Following filtration, aliquot absorbances were measured at 253 mm. Drug content was determined using the calibration curve and the linearity equation.
Drug Deposition Study
The amount of the drug that was deposited on the skin was calculated. After 24 h of permeation testing, the skin membrane was gently removed from the diffusion cell and rinsed with distilled water for 10 s to remove the adhering gel formulation. The skin was then sonicated in 10 mL of methanol for 30 min to leach off the drug. The Ebastine content of methanol was then determined spectrophotometrically.
Gel Strength
A 50 g weight was placed on the surface of the gel and allowed to penetrate through the gel after 30 g of gel was placed in a 50 mL beaker. For each formulation, the time it took the 50 g weight to penetrate 5 cm into the gel was recorded. Each new formulation was subjected to the same technique three times, with the average time being recorded.
In Vitro Diffusion
The in vitro drug diffusion investigation was completed using a simple diffusion cell with different formulations of niosomal nanogel (NF2G1, NF2G2, NF2G3, and NF2G4). An amount of 1 g of niosomal gel was in the donor medium and phosphate buffer at pH 7.4 as the receptor media. The preactivated dialysis membrane was placed between the receptor and donor chambers for the gel formulation. The receptor medium temperature was fixed at 37 °C throughout the experiment, and stirring was performed at a constant 100 rpm. Then, 1 mL samples were withdrawn from the cell and replaced with new a medium at specific time intervals of 0.5, 1, 2, 3, 4, and 8 h. The drug content of the receptor samples was determined using a UV–Vis double-beam spectrophotometer at 253 nm. The cumulative amount of the drug diffused and the diffuse rate was calculated.
2.3.5. Ex Vivo Permeation Study
Ex vivo studies were performed to investigate the release of Ebastine from the optimized niosomal gel (10 mg/gm), whereas pure-drug Ebastine and a niosomal vesicle were used as the control at the same concentration. Fresh goat skin (2.54 ± 0.06 mm) was purchased from the slaughterhouse, cleaned, and the hairs were removed using a depilator (the removal of hair can change the barrier property of skin). The Franz diffusion cell (1 cm2 diffusion area) was filled (receiver compartment) with 20 mL of phosphate buffer (pH 7.4, 37 °C), and 10 mg equivalent niosomal nanogel sample was applied to the donor compartment. The sample aliquots were collected at regular time intervals from the receiver compartment and replaced with the same volume of media. This study was carried out for a period of 10 h and the samples were analyzed for Ebastine content with an UV–Vis double-beam spectrophotometer at 253 nm. The experiment was performed in triplicate.
2.3.6. In Vitro Antimicrobial Activity
Agar Well Diffusion Method
Using the agar well diffusion method, the optimized formulation was tested for antimicrobial activity against S. aureus, one of the microorganisms responsible for urticaria. To inoculate the agar plate surface, a volume of the microbial inoculum was spread throughout the entire agar surface. After diluting the antimicrobial agent or extract solution to the required concentration, a hole with a diameter of 6 to 8 mm was aseptically punched with a sterile cork borer or tip. Following that, the agar plates were incubated at the appropriate temperatures for the test microorganism. The antibiotic component distributes throughout the agar substrate and inhibits the growth of the tested microbiological strain. Petri plates were inspected for zones of inhibition, which were measured on a millimeter scale. The tests were repeated three times to reduce errors.
2.3.7. Stability Study
The stability study of the formulation was performed as per International Council for Harmonization (ICH) guidelines. The freshly prepared formulation was divided into groups and kept at specified storage conditions as per ICH guidelines. Samples were withdrawn periodically and tested for various evaluation parameters mentioned above. The stable formulation must retain the evaluation parameters at specified storage conditions over a period.
3. Results and Discussion
Figure 2 depicts the FTIR spectra of pure Ebastine and the optimized nanogel formulation, which were recorded using a Shimadzu IR Affinity-1S CE, Kyoto, Japan. Major peaks for Ebastine included C–H stretching at 2943 cm
−1 and 2818 cm
−1, C=O stretching at 1677 cm
−1, and O–H bending at 1357 cm
−1. The optimized nanogel formulation exhibited peaks for cholesterol (1465 cm
−1 and 1735 cm
−1), Span 60 (2916 cm
−1 and 1072 cm
−1), and Carbopol 934 (2916.37 cm
−1, 2854.65 cm
−1, 1697.36 cm
−1, and 1458.18 cm
−1). FTIR analysis confirmed compatibility between Ebastine and excipients, showing no potential interaction.
3.1. Box–Behnken Statistical Optimization of Ebastine-Loaded Niosomal Formulation
The results of the experimental design showed that the amount of cholesterol, surfactant, and volume of hydration medium had a significant impact on this system, leading to high drug EE and vesicle sizes during the niosome-manufacturing process. Based on the evaluation of multiple statistical parameters, such as Sequentia
p-values, projected R
2, and adjusted R
2, the model for response analysis was chosen. The selected model should have a lower predicted R
2 value, adjusted R
2 value, and sequential
p-values. Three independent variables were chosen for analysis, and a linear model was used (
Table 5).
3.1.1. Effect on Entrapment Efficiency (Y1)
Based on preliminary studies detailed in
Table 5 and
Figure 3, entrapment efficiency is notably affected by the concentration of surfactant to cholesterol ratio. A higher cholesterol concentration correlates with lower entrapment efficiency. The volume of the hydration medium initially enhances entrapment efficiency, but beyond a certain point, further increases decrease the efficiency. According to the ANOVA report, all independent variables significantly influence this factor (
p-value = 0.0076, <0.050), validating the significance of the linear model.
In
Figure 3 the green represents the area used to select the processing and excipient variable to optimize formulations of good quality.
3.1.2. Zeta Potential (Y2)
Based on
Table 5,
Figure 4, preliminary studies, and ANOVA analysis, it was found that the interaction between the surfactant (
p-value: 0.0367), cholesterol (
p-value: 0.0248), and the hydration medium significantly affects zeta potential. Higher surfactant concentrations contribute to better overall stability of the medium and desired zeta potential values. Conversely, increasing the cholesterol concentration reduces the zeta potential. The
p-value for this factor was 0.0322, indicating the significance of the linear model for predicting zeta potential.
3.1.3. Vesicle Size (Y3)
Based on ANOVA analysis,
Table 5, and
Figure 5, it was observed that the amount of cholesterol (
p-value: 0.2036) and the surfactant (
p-value: 0.0036) significantly influence the vesicle size of niosomes. The HLB value of the surfactant plays a crucial role in determining vesicle size. Higher amounts of cholesterol tend to increase the interlamellar gap in multilamellar vesicle structures, resulting in larger vesicle sizes. The
p-value for this factor was 0.0127, indicating the significance of the linear model in predicting vesicle size.
The polynomial equations of each response generated from the software are given below:
3.2. Characterization of Niosomes Loaded with Ebastine
3.2.1. Optical Microscopy
The photos of Ebastine-loaded niosomes prepared using the thin film hydration method were visualized under an optical microscope (Labline, Vadodara, Gujarat, India) at 40X and 100X.
3.2.2. Entrapment Efficiency
The entrapment efficiency ranged from 50% to 84%, with NF2 exhibiting the maximum entrapment efficiency at 84.19 ± 3.14%.
3.2.3. Transmission Electron Microscopy (TEM)
The size of the niosomes was measured using Transmission Electron Microscopy (TEM) (Jeol/JEM 2100, Tokyo, Japan), and their structure is depicted in the photos below (
Figure 6).
3.2.4. Size Distribution and Polydispersity Index (PDI)
The average size of the niosomes was determined to be 276 ± 63.22 d.nm, with a polydispersity index (PDI) of 0.529 (
Figure 7A).
3.2.5. Zeta Potential
A zeta potential of −27 mV ± 5.46 mV (
Figure 8B) indicates good colloidal stability for niosomes, as the negative surface charge provides sufficient electrostatic repulsion to prevent aggregation.
3.3. Characterization of Nanogel Loaded with Ebastine Niosomes
3.3.1. Homogeneity and Grittiness
The homogeneity and grittiness of NF3G2 were superior to the other formulations; no apparent particulate matter was observed in NF3G2 under an optical microscope. Consequently, it meets the criteria for being free of particulate matter.
3.3.2. pH Determination
The pH of all formulated gels was found to be in the range of 7.1–7.4, indicating that all formulations are near a neutral pH (
Table 6).
3.3.3. Viscosity
The viscosity of the niosomal gel was evaluated using a Brookfield viscometer (DV2T model) with a Helipath spindle T series (D94). NF3G2 demonstrated appropriate viscosity compared to NF3G1, which was less viscous, and NF3G3 and NF3G4, which were highly viscous (
Table 6).
3.3.4. Spreadability
The spreadability refers to how quickly the gel spreads when a small amount of shear is applied. NF3G1 and NF3G2 exhibited better spreadability, as indicated in
Table 6.
3.3.5. Extrudability
The amount of gel that is extruded through the tube’s opening when pressure is applied was used to gauge extrudability. The extrudability of the NF3G2 gel was found to be better compared to other formulations, as indicated in
Table 6.
3.3.6. Drug Content
NF3G2 exhibited the highest drug content (85.26 ± 5.21%) compared to the other prepared gels. The drug content ranged from 60% to 86% across the formulations (
Table 6).
3.3.7. Drug Deposition
The amount of medication deposited on the transdermal layer after 24 h of diffusion was found to be lowest for NF3G2, at 14.27 ± 2.50%. This indicates that 83.22 ± 6.12% of the drug was released during the diffusion. Therefore, NF3G2 appears to be preferable to the other formulations
Table 6.
3.3.8. Gel Strength
Gel strength, which indicates the gel’s tensile strength and its ability to withstand external pressure, was good across all formulations. Values ranged from 32 ± 1.2 sec for NF3G1 to 44 ± 1.5 sec for NF3G4 (
Table 6).
3.3.9. In Vitro Antimicrobial Activity
Antimicrobial activity was assessed by measuring the zone of inhibition of the optimized niosomal gel against
S. aureus, which are also responsible factors for urticaria. The zone of inhibition for
S. aureus was found to be 36 mm for pure-drug Ebastine (
Figure 8A) and 41 mm for the Ebastine–niosomal gel (
Figure 8B), indicating that the gel works more effectively than pure Ebastine.
3.3.10. In Vitro Diffusion Study and Kinetic Modeling
The NF3G2 formulation shows the maximum drug release of 83.22 ± 6.12% at 8 h. The kinetic studies interpret that the NF3G2 formulation follows a Korsmeyer–Peppas model, as the R2 for this model was found to be more in comparison to the other models, which was 0.915.
3.3.11. Ex Vivo Permeation Study
In a skin permeation study using a Franz diffusion cell on goat skin, NF3G2 Ebastine-loaded niosomal nanogel showed significantly higher drug permeation rates compared to pure Ebastine drug and Ebastine-loaded niosomal vesicles (Carbopol 1%). The optimized formulation achieved drug permeation percentages of 35.50%, 52.88%, and 69.99%, respectively, as depicted in
Figure 9, demonstrating its enhanced permeation capability.
3.3.12. Stability Studies
NF3G2, the optimized niosomal nanogel formulation, was stored at 40 ± 2 °C/75% RH for 90 days. The periodic evaluation of pH, % drug content, and in vitro drug diffusion revealed consistent and satisfactory results. No significant changes were observed in the formulation during the storage period.
4. Conclusions
EBT-loaded niosomes, prepared using the thin film hydration method and optimized with Box–Behnken experimental design, significantly increased the bioavailability of Ebastine. These niosomes demonstrated high entrapment efficiency (up to 84.19 ± 3.14%), a polydispersity index (PDI) of 0.529, and a stable zeta potential of −27.7 ± 5.46 mV. The niosomal nanogel formulation showed a drug content of 85.26 ± 5.21%. The best results were achieved with a 1% Carbopol 934 polymer niosomal nanogel, which exhibited good antimicrobial activity against S. aureus, highlighting its potential for treating urticaria and other skin allergies more effectively than conventional formulations. It could be the best possible approach to treat allergic conditions to deliver the drug via a transdermal route for more effective treatment.
Author Contributions
Conceptualization, B.R.R. and A.P.P.; methodology, B.R.R. and A.P.P.; software, B.R.R. and A.P.P.; formal analysis, B.R.R. and A.P.P.; investigation, B.R.R. and A.P.P.; resources, B.R.R. and A.S.J.; data curation, A.P.P. and B.R.R.; writing—original draft preparation, B.R.R. and A.P.P.; writing—review and editing, A.P.P., B.R.R., and A.S.J.; visualization, B.R.R. and A.S.J.; supervision, B.R.R.; funding acquisition, A.S.J. All authors have read and agreed to the published version of the manuscript.
Funding
This research received no external funding.
Institutional Review Board Statement
Not applicable.
Informed Consent Statement
Not applicable.
Data Availability Statement
Data are contained within the article.
Acknowledgments
This work is supported and fortified by Shri D.D. Vispute College of Pharmacy and Research Center, Panvel, India.
Conflicts of Interest
The authors declare no conflicts of interest.
References
- Langer, R. Transdermal Drug Delivery: Past Progress, Current Status, and Future Prospects. Adv. Drug Deliv. Rev. 2004, 56, 557–558. [Google Scholar] [CrossRef] [PubMed]
- Barry, B.W. Breaching the Skin’s Barrier to Drugs. Nat. Biotechnol. 2004, 22, 165–167. [Google Scholar] [CrossRef] [PubMed]
- Honeywell-Nguyen, P.L.; Bouwstra, J.A. Vesicles as a Tool for Transdermal and Dermal Delivery. Drug Discov. Today Technol. 2005, 2, 67–74. [Google Scholar] [CrossRef] [PubMed]
- Tahamtan, S.; Shirban, F.; Bagherniya, M.; Johnston, T.P.; Sahebkar, A. The Effects of Statins on Dental and Oral Health: A Review of Preclinical and Clinical Studies. J. Transl. Med. 2020, 18, 155. [Google Scholar] [CrossRef] [PubMed]
- Bhardwaj, P.; Tripathi, P.; Gupta, R.; Pandey, S. Niosomes: A Review on Niosomal Research in the Last Decade. J. Drug Deliv. Sci. Technol. 2020, 56, 101581. [Google Scholar] [CrossRef]
- Sharma, R.; Due, J.S.; Parsed, D.N. An Overview on Niosomes: Novel Pharmaceutical Drug Delivery System. J. Drug Deliv. Ther. 2022, 12, 171–177. [Google Scholar] [CrossRef]
- Madame, V.B.; Mokale, V.J. Niosomes as an Ideal Drug Delivery System. J. NanoSci. Res. Rep. 2021, 3, 1–9. [Google Scholar] [CrossRef]
- Akbarzadeh, I.; Sedaghatnia, K.; Bourbour, M.; Moghaddam, Z.; Moghtaderi, M.; Samimi-Sohrforozani, E.; Quazi, S.; Far, B. Niosomes: A Novel Targeted Drug Delivery System. Preprints 2021, 2021120315. [Google Scholar] [CrossRef]
- Suchithra, A.B.; Jeganath, S.; Jeevitha, E. Pharmaceutical Gels, and Recent Trends—A Review. Res. J. Pharm. Technol. 2019, 12, 6181. [Google Scholar] [CrossRef]
- Liu, K.H.; Kim, M.G.; Lee, D.J.; Yoon, Y.J.; Kim, M.J.; Shon, J.H.; Choi, C.S.; Choi, Y.K.; Desta, Z.; Shin, J.G. Characterization of Ebastine, Hydroxyebastine, and Carebastine Metabolism by Human Liver Mi crosomes and Expressed Cytochrome P450 Enzymes: Major Roles for CYP2J2 and CYP3A. Drug Metab. Dispos. 2006, 34, 1793–1797. [Google Scholar] [CrossRef] [PubMed]
- Bhasha, S.A. Recent Trends in Usage of Polymers in the Formulation of Dermatological Gels. Indian J. Res. Pharm. Biotechnol. 2013, 1, 161–168. [Google Scholar]
- Rane, S.; Inamdar, Y.; Rane, B.; Ashish, J. Niosomes: A non-ionic surfactant based vesicles as a carriers for drug delivery. Int. J. Pharm. Sci. Rev. Res. 2018, 51, 198–213. [Google Scholar]
- Kauslya, A.; Borawake, P.D.; Shinde, J.V.; Chavan, R.S. Niosomes: A novel carrier drug delivery system. J. Drug Deliv. Ther. 2021, 11, 162–170. [Google Scholar] [CrossRef]
- Shah, P.; Goodyear, B.; Haq, A.; Puri, V.; Michniak-Kohn, B. Quality by design: A systematic approach using an advanced statistical tool to optimization of niosomes preparation for the topical delivery. Therapy 2020, 6, 251–277. [Google Scholar]
- Zaid Alkilani, A.; Hamed, R.; Abdo, H.; Swellmeen, L.; Basheer, H.A.; Wahdan, W.; Abu Kwiak, A.D. Formulation and evaluation of azithromycin-loaded niosomal gel: Optimization, in vitro studies, rheological characterization, and cytotoxicity study. ACS Omega 2022, 7, 39782–39793. [Google Scholar] [CrossRef] [PubMed]
- Mhatre, N.R.; Rane, B.R.; Padave, A.P.; Jain, A.S. Bilastine-Loaded Transethosome Base Nanogel for the Treatment of Allergic Reactions: An In vitro Characterization. Micro Nanosyst. 2024, 16, 219–233. [Google Scholar] [CrossRef]
- Rane, B.; Gadekar, P.; Patil, V.; Amkar, A.; Jain, A. Fabrication and Optimization of Febuxostat-loaded Liposomal Gel Using the Box–Behnken Design for Gout Treatment. Nano Biomed. Eng. 2024, 16, 484–497. [Google Scholar] [CrossRef]
| Disclaimer/Publisher’s Note: The statements, opinions and data contained in all publications are solely those of the individual author(s) and contributor(s) and not of MDPI and/or the editor(s). MDPI and/or the editor(s) disclaim responsibility for any injury to people or property resulting from any ideas, methods, instructions or products referred to in the content. |
© 2025 by the authors. Licensee MDPI, Basel, Switzerland. This article is an open access article distributed under the terms and conditions of the Creative Commons Attribution (CC BY) license (https://creativecommons.org/licenses/by/4.0/).